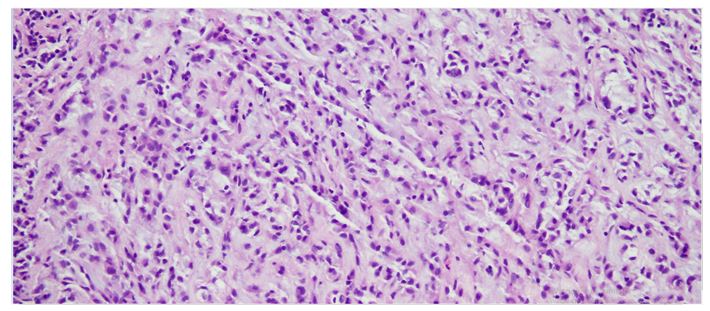
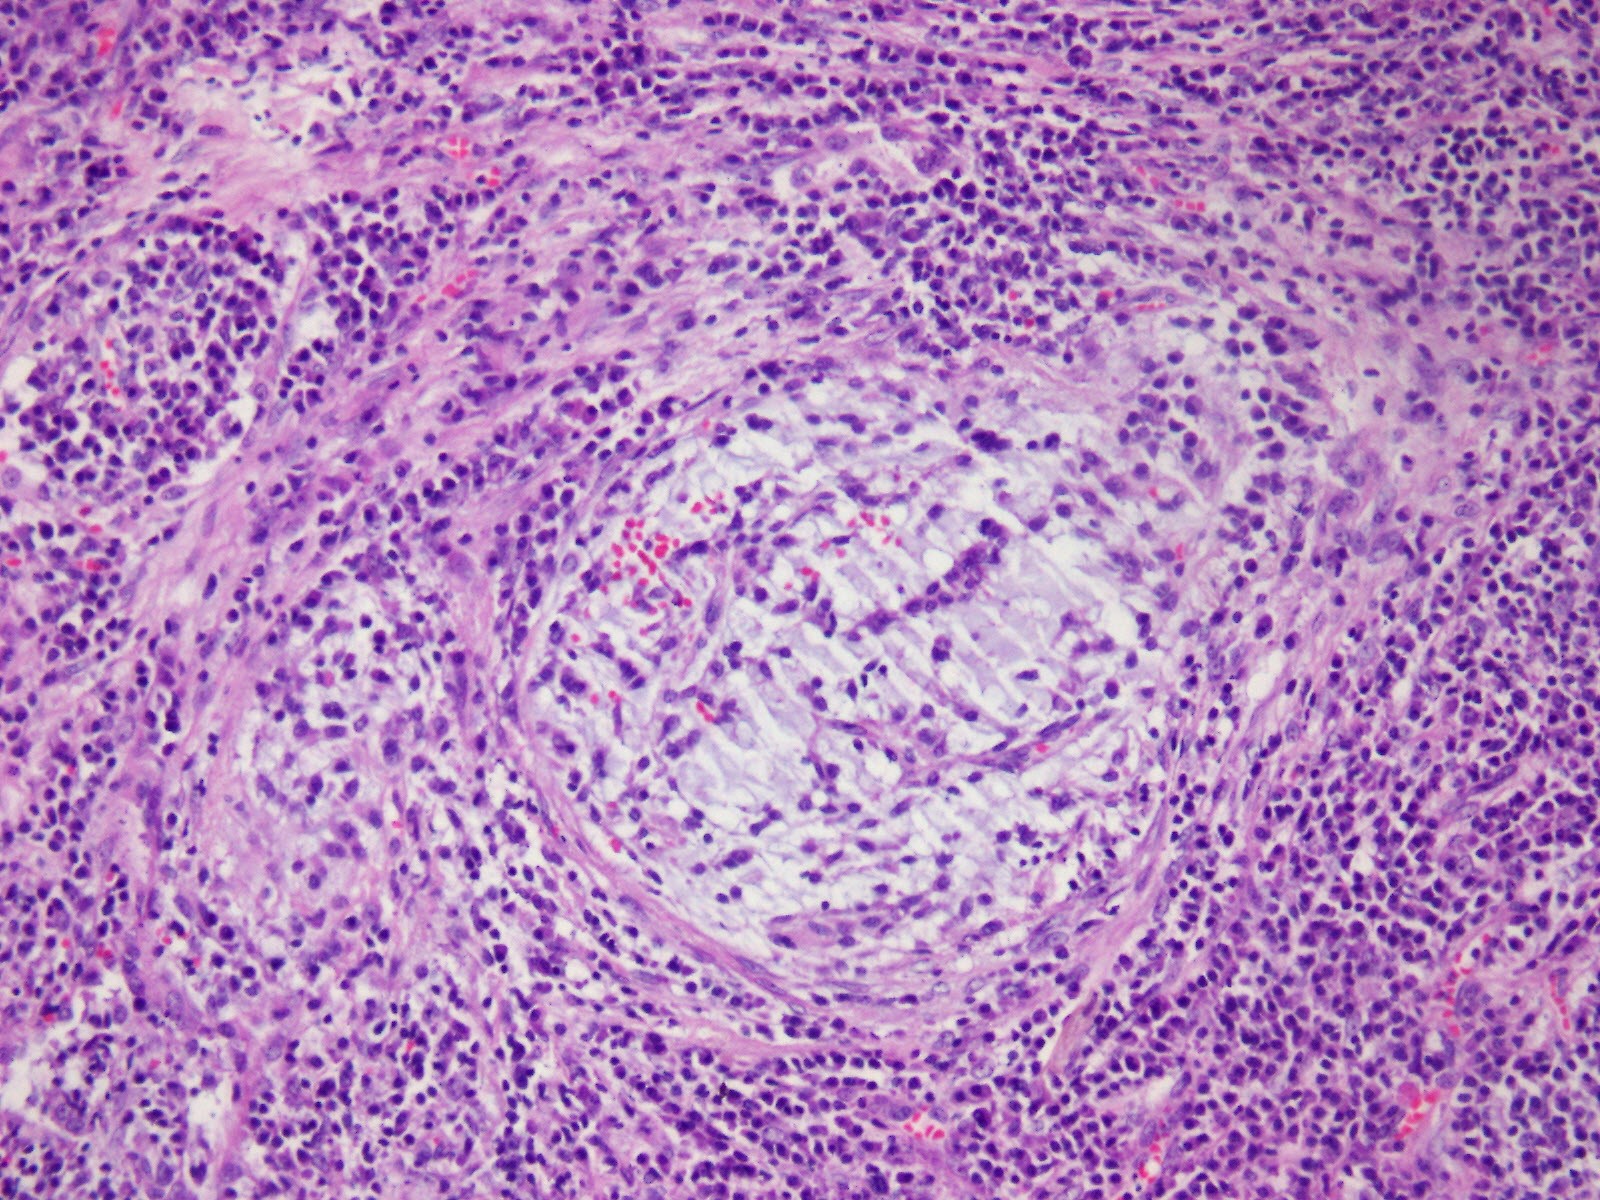

Primary Pulmonary Myxoid Sarcoma with EWSR1:ATF1 Fusion: A Case Report
Received Date: September 11, 2025 Accepted Date: September 26, 2025 Published Date: September 30, 2025
doi:10.17303/joo.2025.1.103
Citation: Neslihan Akanil Fener, Aysu Sinem Koç, Ebru Taştekin, Büge Öz, Levent Cansever (2025) Primary Pulmonary Myxoid Sarcoma with EWSR1:ATF1 Fusion: A Case Report. J Oncogenomics and Oncotarget 3: 1-8
Abstract
Introduction: Primary pulmonary myxoid sarcoma is a rare lung tumor that primarily affects the central lung and is associated with the EWSR1::CREB1 fusion.
Case Presentation: We report an exceptional case of primary pulmonary myxoid sarcoma arising in the peripheral lung and harboring a EWSR1:ATF1 gene fusion. A 46-year-old female presented with a solid nodule in the left lower lobe, which was resected with a wedge. The tumor was composed of reticular proliferation of homogeneous moderately abnormal spindle cells within an abundance of myxoid stroma. Immunohistochemcial stains showed that the tumour was positive for SMA (Smooth muscle actin) and negative for demsin. EWSR1 and ATF1 gene rearrangements were validated using next-generation sequencing (NGS).
Discussion: Pathological signs and gene rearrangements are critical for determining the presence of primary pulmonary myxoid sarcoma. Complete resection and close monitoring are required.
Keywords: Primary; Myxoid Sarcoma; Lung; EWSR1 -ATF1; Translocation
Introduction
Primary pulmonary myxoid sarcoma is a low-grade sarcoma with a frequency of about 0.2% [1]. Nicholson originally reported it in 1999 with two examples of low-grade mucinous tumor in the bronchus [2]. Thway discovered that the tumor possesses a characteristic chromosomal translocation of t (2; 22) (q33; q12), which leads to the EWSR1-CREB1 fusion in 2011. As a result, he renamed it the EWSR-CREB1 fusion gene of primary pulmonary myxoid sarcoma [3]. The tumor was first classified as a pulmonary mesenchymal tumor in the World Health Organization's lung tumor tissue classification in 2015 [4]. We present a case of PPMS with endobronchiolar location in which a EWSR1::ATF1 alternative gene fusion was discovered.
Case Presentation
In April 2022, a 45-year-old female patient had Covid 19 and in thorax computed tomography (CT), a 1 cm diameter nodule was discovered in the left lower lobe (Figure 1). Bronchoscopic and cytological testing revealed no abnormalities. Positron emission tomography-CT was performed and late fluorodeoxyglucose uptake (FDG) SUVmax was 2.7. Malignancy could not be ruled out and left lower wedge resection was performed on the patient. In frozen section, it was shown to be benign. The final pathology report revealed that the patient had primary myxoid pulmonary sarcoma. The patient had a lower left lobectomy. At 6 months following surgery, the patient is doing well and there has been no recurrence.
The tumor was a solitary, endobronchial, well-circumscribed mass with a fleshy uniform white and gelatinous cut surface that measured 2x1.7x1 cm. histologically, the tumour was multinodular, and its cells were small, ovoid or polygonal with vesicular nuclei resembling chondrocyte-like or physaliferous cells in a background of myxoid stroma (Figure 2). There were infrequent mitotic figures, as well as extensive lymphoplasmacytic cell infiltration (Figure 3).
Frozen sections revealed spindle cell proliferative lesions with a rich mucoid background and a significant lymphocyte and plasma cell infiltration. It was impossible to tell if it was benign or cancerous. The tumor cells were distributed in a nodular pattern with considerable collagen interstitium, according to H&E staining. Tumor cells were spherical and oval, organized reticularly or ribbon-like in a mucoid background (Figure 2,3). Tumor cell atypia was mild to moderate. Mitotic activity was less than 2/10 HPF (high-power fields). The tumor had a mucinous background, many lymphocytes and plasma cells in the infiltrate, and many spindle cells proliferated (Figure 4).
Immunophenotypical results were negative for CK-pan, TTF-1, smooth muscle actin (SMA), S100, Desmin, CD34, CD31, and CD56; localized expression of epithelial membrane antigen (EMA) (Figure 5). The Ki67 proliferation index was low, approximately 10% (Figure 6).
In this case, Illumina NextSeq 550 system, Qiaseq Targeted RNA design (CFHS-14653Z-214) was used to screen those genes: ALK, AKAP9, BRAF, BRD4, CLCN6, EGFR, EML4, ERG, ETV1, ETV4, ETV6, EWSR1, FAM131B, FGFR1, FGFR2, FGFR3, FUS, GNAI1, HEY1, JAZF1, KIAA1549, KIF5B, MAML2, MET, MN1, MYB, MYBL1, NAB2, NOTCH2, NPM1, NRG1, NTRK1, NTRK2, NTRK3, NUTM1, NUTM2A, PAX3, PDGFRA, PDGFRB, RET, ROS1, SSX1, SSX2, SRF, STRN, TERT, TFE3, TFG, TRIM24, YAP1. An EWSR1::ATF1 alternative gene fusion has been discovered. Exon 6 of EWSR1's chromosome 22 and exon 5 of ATF 1's chromosome 12 contain the fusion locus. There were no additional mutations discovered in this case. The patient was diagnosed with primary pulmonary myxoid sarcoma with EWSR1::ATF1 fusion.
Discussion
PPMS are a rare primary lung mesenchymal tumor with specific clinicopathological, immunophenotypic, and molecular-genetic characteristics. Nicholson et al. reported PPMS for the first time in 1999 [2]. Thway et al. termed it PPMS in 2011 after discovering it through analysis of the genetic properties of EWSR1-CREB1[3]. The WHO classified PPMS as a lung mesenchymal tumor for the first time in 2015 [4].
PPMS is an extremely uncommon intrapulmonary tumor that arises from large bronchi in young adults with a female predominance (female to male ratio of 1.5:1) [3,5]. Centrally situated instances exhibit cough, sputum, hemoptysis, and weight loss. This tumor is frequently discovered by chance during a routine health checkup[5]. In our situation, a lesion was discovered during the thorax CT for Covid 19. PET imaging reveals that PPMS has limited 18-fluorodeoxyglucose uptake [6]. PPMS are frequently centrally located, whereas peripherally localised cases are extremely uncommon. In our instance, the lesion was peripherally located and had a mild FDG uptake (SUV maximum: 2.7). There are five cases in the literature that have no relation with the bronchopulmonary tree [3,5]. Endobronchiolar localisation is also present in our case.
AFH is typically a benign tumour of soft tissue that has been infrequently reported in the lung [3]. Significant overlap exists between PPMS and primary pulmonary AFH, posing a diagnostic challenge, particularly when there is a myxoid change in AFH. Both PPMS and AFH can be nodular or multinodular and can develop in or near the main airways. Infrequently observed in thoracic AFH, focal haemorrhage can be observed in PPMS [7]. According to the literature, the following characteristics may be useful for distinguishing between two entities. First, the myxoid stroma of pulmonary AFH is frequently focal [3]. Secondly, a peritumoral lymphoid cuff and whorled or storiform patterns are distinguishing characteristics of AFH that are not typically observed in PPMS [8]. Thirdly, PPMS is consistently positive for focal/weak EMA but negative for the majority of other lineage markers including TTF1, S100, and cytokeratin [9]. Gui et al. reported a case with endobonchial localization in November 2020, and Nishimura reported a case with subpevral peripheral EWSR1-ATF fusion transcript in February 2023 [5,6]. Although EWSR1-CREB1 and EWSR1-ATF1 fusions continue to be reported in an increasing variety of neoplasms, the mechanisms by which they contribute to oncogenesis are yet to be understood. It is not yet clear why certain genes have a propensity to partner with others, although this might be partly because of the proximity of 2 sets of genes within the 3-dimensional arrangement of chromosomes within the nucleus [1].
Conclusion
In PPMS, we identified a second case of endobronchiolar localization due to EWSR1 and ATF1 gene rearrangements. In general, all patients have surgical excision and intensive monitoring, including wedge resection, segment resection, lobectomy, and pneumonectomy. Under general anesthesia, the patient had thoracoscopic right upper lobectomy and lymph node dissection in our instance. Despite the tumor's prognosis, kidney metastasis, brain metastasis, and contralateral lung metastases were detected in a few patients [3,10,11]. As a result, full resection and close surveillance are required.
Author Contributions
Concept –N.A.F., A.S.K.; Design - N.A.F.; Supervision - E.T.; Data Collection and/or Processing - N.A.F., A.S.K., B.Ö.,L.C.; Literature Review - N.A.F.; Writer – N.A.F., A.S.K.
Author Contribution
Neslihan Fener, Aysu Sinem Koç, Ebru Taştekin, Büge Oz and Levent Cansever designed the case report and wrote the initial draft of the manuscript. All other authors have contributed to data collection and interpretation and have critically reviewed the manuscript.
Funding
The authors received no financial support for publication of this article.
Compliance with Ethical Standards
Conflict of Interest
The authors declare that they have no conflict of interest.
Statement of informed consent Informed consent was obtained from all individual participants involved in this study.
- Attanoos RL, Appleton MAC, Gibbs AR (1996) Primary sarcomas of the lung: a clinicopathological and immunohistochemical study of 14 cases. Histopathology 29: 29-36.
- Nicholson, Baandrup, Florio, et al. (1999) Malignant myxoid endobronchial tumour: a report of two cases with a unique histological pattern: Malignant endobronchial myxoid tumour. Histopathology 35: 313-8.
- Thway K, Nicholson AG, Lawson K, et al. (2011) Primary Pulmonary Myxoid Sarcoma with EWSR1-CREB1 Fusion: A New Tumor Entity. The American Journal of Surgical Pathology 35: 1722.
- Travis WD, Brambilla E, Nicholson AG, et al. (2015) The 2015 World Health Organization Classification of Lung Tumors: Impact of Genetic, Clinical and Radiologic Advances Since the 2004 Classification. Journal of Thoracic Oncology 10: 1243-60.
- Nishimura T, Ii T, Inamori O, et al. (2023) Primary Pulmonary Myxoid Sarcoma with EWSR1::ATF1 Fusion: A Case Report. Int J Surg Pathol 31: 88-91.
- Gui H, Sussman RT, Jian B, et al. (2020) Primary Pulmonary Myxoid Sarcoma and Myxoid Angiomatoid Fibrous Histiocytoma: A Unifying Continuum With Shared and Distinct Features. American Journal of Surgical Pathology 44: 1535-40.
- Smith SC, Palanisamy N, Betz BL, et al. (2014) At the intersection of primary pulmonary myxoid sarcoma and pulmonary angiomatoid fibrous histiocytoma: observations from three new cases.
- Chen Z, Yang Y, Chen R, et al. (2020) Primary pulmonary myxoid sarcoma with EWSR1-CREB1 fusion: a case report and review of the literature. Diagn Pathol 15: 15.
- Prieto-Granada CN, Ganim RB, Zhang L, et al. (2017) Primary Pulmonary Myxoid Sarcoma: A Newly Described Entity—Report of a Case and Review of the Literature. Int J Surg Pathol 25: 518-25.
- Jeon YK, Moon KC, Park S-H, et al. (2014) Primary pulmonary myxoid sarcomas with EWSR1-CREB1 translocation might originate from primitive peribronchial mesenchymal cells undergoing (myo)fibroblastic differentiation. Virchows Arch 465: 453-61.
- Agaimy A, Duell T, Morresi-Hauf AT (2017) EWSR1-fusion-negative, SMARCB1-deficient primary pulmonary myxoid sarcoma. Polish Journal of Pathology 68: 261-7.

Figures at a glance